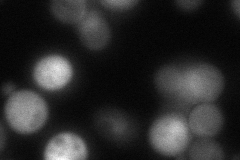
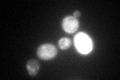
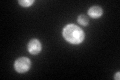

View description
Kynurenine aminotransferase, catalyzes formation of kynurenic acid from kynurenine; potential Cdc28p substrate
Localization:
Intensity:
Fold change:
Significance:
-
C’ GFP library in SD

cytosol:mitochondria53.37 -
N' NOP1pr-GFP in SD

mitochondria158.674 -
N' TEF2pr-mCherry in SD

mitochondria262.232 -
N' NATIVEpr-GFP in SD
cytosol51.9484 -
N' TEF2pr-VC and Cyto-VN in SD

#N/A0 -
C’ GFP library in SD+DTT
cytosol.mitochondria83.971.57Yes -
C’ GFP library in SD+H2O2

cytosol.mitochondria82.231.54Yes -
C’ GFP library in Starvation Media
cytosol,mitochondria223.974.19Yes -
C’ GFP library on the background of Pup2-DaMP

cytosol:mitochondria -
C’ GFP library on the background of CCT mutant

cytosol:mitochondria60.21021.12801No
